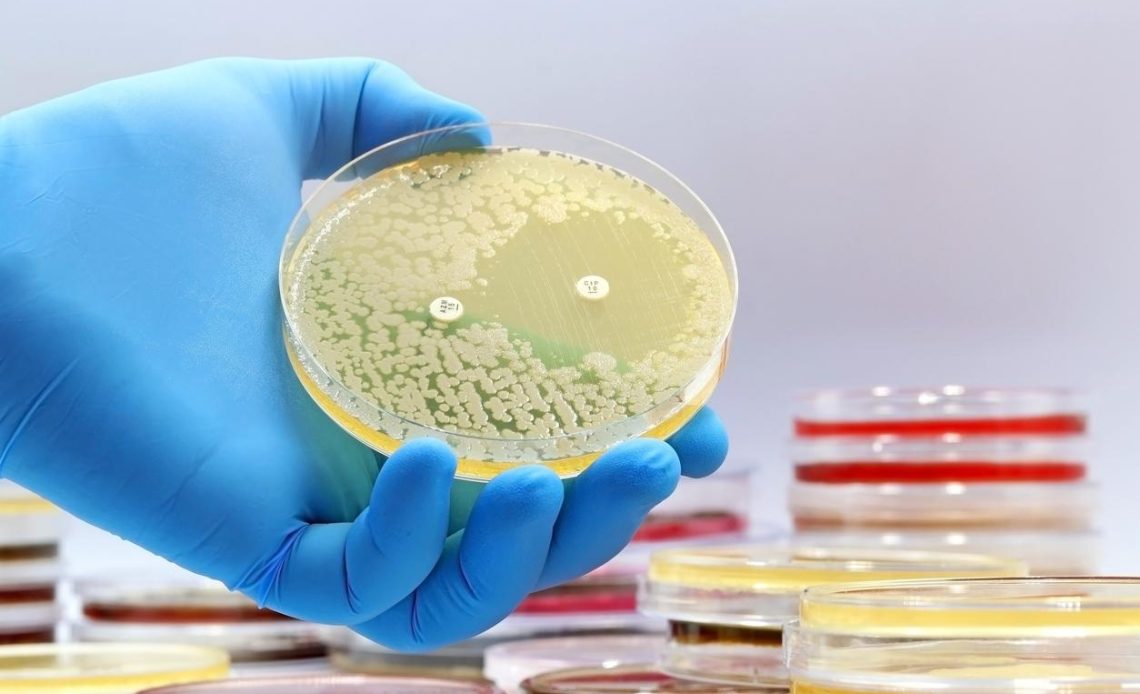

Antibiotic resistance is one of the most urgent and complex challenges facing global healthcare today. The rapid rise of resistant bacteria threatens to undo the progress made in modern medicine, making once-treatable infections potentially deadly. For years, public health officials have raised the alarm about this looming crisis, and while much attention has been given to the potential dangers of resistance, substantial progress is being made in understanding and combating it.
In this article, we explore the future of antibiotic resistance by examining the real results from recent research, the strategies being employed to mitigate resistance, and what the future holds in terms of potential solutions.
Understanding the Crisis: The Scope of Antibiotic Resistance
Antibiotic resistance occurs when bacteria evolve mechanisms to withstand the drugs that would typically kill them or inhibit their growth. This phenomenon arises from the overuse and misuse of antibiotics, both in humans and in animals, as well as inadequate infection control measures in hospitals and clinics. As bacteria become more resistant, infections become harder to treat, leading to longer hospital stays, increased medical costs, and higher mortality rates.
The World Health Organization (WHO) has declared antibiotic resistance one of the top ten global public health threats. In fact, it is estimated that by 2050, antibiotic-resistant infections could lead to as many as 10 million deaths annually worldwide, surpassing cancer as a leading cause of death. This stark forecast underscores the urgency with which we must address the issue.
Real Results in the Fight Against Antibiotic Resistance
Despite the daunting predictions, significant strides are being made in the battle against antibiotic resistance. While the challenge is immense, the scientific community has responded with innovative research, new treatment strategies, and policy reforms aimed at curbing the rise of resistant bacteria.
1. New Antibiotics and Antibiotic Alternatives
For years, the development of new antibiotics slowed dramatically, largely due to the financial and regulatory challenges faced by pharmaceutical companies. However, recent efforts show promise in reversing this trend. A number of new antibiotics have been developed in recent years, and several others are in the pipeline.
In 2020, the FDA approved cefiderocol, a novel antibiotic that shows promise against resistant strains of bacteria, including those that cause pneumonia and urinary tract infections. This drug works by bypassing the bacterial mechanisms that typically block antibiotics, allowing it to penetrate and kill bacteria even when they are resistant to other treatments.
Moreover, scientists are looking beyond traditional antibiotics to alternative treatments. Phage therapy, for instance, uses bacteriophages—viruses that infect and kill bacteria. Research into phage therapy is advancing, with clinical trials showing promising results in treating infections that have not responded to antibiotics. While still in the experimental stages, phage therapy could become an important tool in the fight against multi-drug-resistant organisms.
Another alternative gaining traction is the use of antimicrobial peptides (AMPs), naturally occurring molecules found in the human body that can fight off bacterial infections. Researchers are working to synthetically create and modify AMPs for use in treating resistant infections, and early studies suggest they could be effective against superbugs like MRSA (methicillin-resistant Staphylococcus aureus) and E. coli.
2. Antibiotic Stewardship Programs
One of the most effective strategies in combating antibiotic resistance is the implementation of antibiotic stewardship programs (ASPs). These programs are designed to ensure the appropriate use of antibiotics, preventing unnecessary prescriptions and reducing the likelihood of resistance developing.
Real-world data demonstrates the effectiveness of ASPs. A study published in the Lancet Infectious Diseases showed that hospitals with robust antibiotic stewardship programs saw a significant reduction in the use of broad-spectrum antibiotics, which are often the culprits in resistance development. These hospitals also experienced lower rates of healthcare-associated infections and improved patient outcomes.
In the U.S., the CDC has emphasized the importance of ASPs in both hospital and outpatient settings. Hospitals that follow stewardship guidelines see a decrease in antibiotic-resistant infections, reduced healthcare costs, and better overall patient care. This focus on targeted therapy, rather than a one-size-fits-all approach, is an essential part of the fight against resistance.
3. Global Policy and Regulatory Reforms
Addressing antibiotic resistance requires a global effort. In recent years, the international community has begun to take more decisive action. In 2015, the United Nations adopted a political declaration calling for a global action plan to combat antimicrobial resistance (AMR). This plan focuses on strengthening national action plans, improving surveillance of resistance patterns, and ensuring access to quality antibiotics, while also promoting alternatives to antibiotics in agriculture.
At the European Union level, a “One Health” approach has been promoted, recognizing that human, animal, and environmental health are interconnected. This approach encourages policies to reduce the use of antibiotics in agriculture, where overuse of antibiotics in livestock farming has been a major contributor to resistance. The EU has also taken steps to regulate the approval and use of antibiotics, encouraging the use of vaccines and other preventive measures to reduce the need for antibiotics in the first place.
In the U.S., the FDA has introduced measures to reduce the use of antibiotics in agriculture, such as guidelines for limiting the use of antibiotics for growth promotion in healthy animals. While challenges remain in fully implementing these reforms worldwide, the shift towards coordinated, global action is a promising sign.
4. Vaccines and Preventive Measures
Vaccines play a crucial role in reducing the need for antibiotics by preventing infections in the first place. By preventing bacterial infections such as pneumonia, meningitis, and tuberculosis, vaccines reduce the reliance on antibiotics, thus slowing the development of resistance.
Recent advances in vaccine development have shown that they can help reduce the burden of antibiotic-resistant infections. For example, the development of the 13-valent pneumococcal conjugate vaccine (PCV13) has significantly reduced the incidence of infections caused by Streptococcus pneumoniae, a common pathogen responsible for pneumonia and other serious diseases. This, in turn, has reduced the need for antibiotics, which helps in curbing resistance.
Moreover, research is ongoing to develop vaccines for other bacterial infections that commonly lead to antibiotic resistance, such as E. coli and Staphylococcus aureus. Vaccines represent a long-term strategy to prevent infections from taking hold, minimizing the need for antibiotics and thereby reducing the potential for resistance.
The Future: A Multifaceted Approach
Looking to the future, the fight against antibiotic resistance will require a multifaceted approach that involves scientific innovation, prudent antibiotic use, global collaboration, and robust policy implementation. Real results are already emerging from the work of researchers, healthcare professionals, and policymakers who are dedicated to addressing this crisis. The development of new antibiotics, alternative therapies, and vaccines offers hope for a future where resistance is kept in check.
However, to succeed, it will require continued investment in research and development, stricter regulations on antibiotic use, and greater public awareness of the issue. The burden of antibiotic resistance cannot be overstated, but with concerted effort and smart, ethical practices, we can ensure that future generations have access to the antibiotics they need to fight infections, without succumbing to the dangers of resistance.
The future of antibiotic resistance may be uncertain, but one thing is clear: the real results we see today are laying the groundwork for a more sustainable and effective approach to treating bacterial infections tomorrow. With a unified effort, we can turn the tide against antibiotic resistance and protect the progress we’ve made in medicine.

